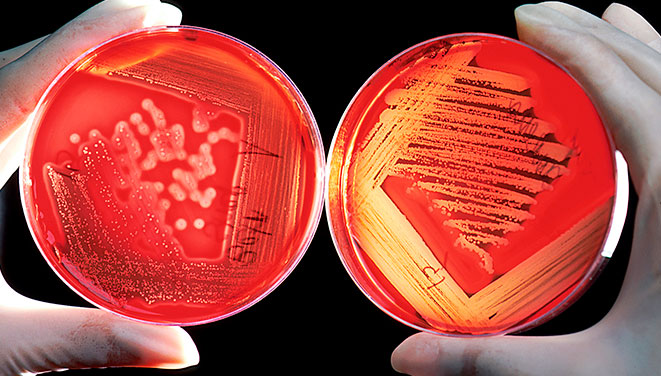

La importància de la microbiologia en l’evolució sanitaria actual
Per a les persones que heu pres la decisió d’estudiar dietètica, un dels temes més importants que treballareu es la microbiologia. I us preguntareu en
Per a les persones que heu pres la decisió d’estudiar dietètica, un dels temes més importants que treballareu es la microbiologia. I us preguntareu en
Vitae Alumni: una xarxa de suport contínua per a graduats, oferint orientació professional i accés a oportunitats laborals exclusives.
Programa de Mobilitat Vitae: experiències internacionals amb Erasmus+ per formar professionals globals i empàtics.
El campus virtual et permet accedir a tota la informació acadèmica. Forma’t i creix a l’Escola de l’Esport i la Salut.
Descobreix el Mètode Vitae: aprenentatge pràctic en esport i salut, amb enfocament científic i personalitzat per l’èxit estudiantil.
Coneix al nostre equip: experts apassionats i qualificats que combinen teoria i pràctica per una educació innovadora i rellevant.
Un ecosistema d’innovació en esport i salut, fomentant sinergies per impulsar les empreses i l’emprenedoria.
Al Centre de Fisioteràpia Vitae, oferim una àmplia gamma de tractaments especialitzats per millorar el teu benestar físic.
All donations to the Student Emergency Fund will directly support our students as they adapt to changing circumstances.